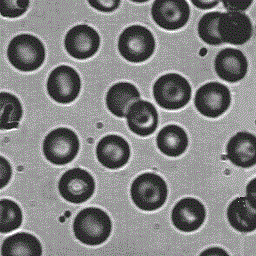
Matlab: Use the discrete wavelet transform, dwt2 in matlab to compress blood256.gif

Question: Matlab: Use the discrete wavelet transform, dwt2 in matlab to compress blood256.gif image down to 25%. This means that you keep the approximation coefficients and
Matlab:
Use the discrete wavelet transform, dwt2 in matlab to compress blood256.gif image down to 25%. This means that you keep the approximation coefficients and replace all other detail coefficients with zeros which reduces the image to one fourth of the original size. Reconstruct the image and find the rms error and the psnr. Display the output.
Step by Step Solution
There are 3 Steps involved in it
Get step-by-step solutions from verified subject matter experts
